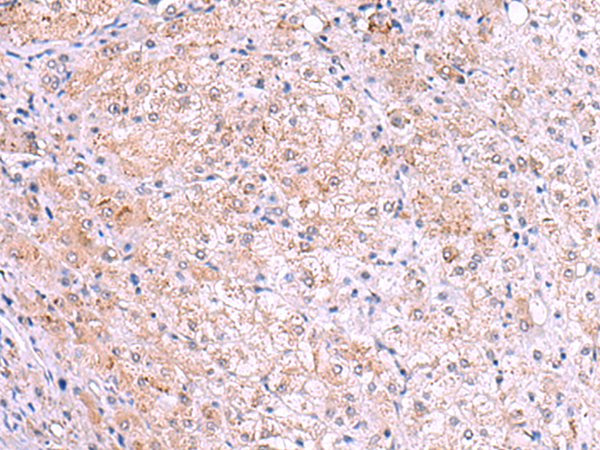

-
分类: 科研抗体货号: P03317别名: E25; BRI3; E25C; ITM3; BRICD2C应用: WB反应种属: Human, Mouse
-
分类: 科研抗体货号: P03231别名: NPH1; JBTS4; SLSN1应用: WB,IHC反应种属: Human, Mouse
-
分类: 科研抗体货号: P03162别名: XE7; 721P; XE7Y; CCDC133; CXYorf3; PRKA17A; SFRS17A; AKAP-17A; DXYS155E应用: IHC反应种属: Human
-
分类: 科研抗体货号: P03310别名: ZNT6; MST103; MSTP103应用: WB,IHC反应种属: Human, Mouse
-
分类: 科研抗体货号: P03228别名: RAY应用: IHC反应种属: Human, Mouse, Rat
-
分类: 科研抗体货号: P03160别名: KIR; NKB1; NKAT3; NKB1B; NKAT-3; CD158E1; KIR3DL1/S1应用: WB,IHC反应种属: Human
-
分类: 科研抗体货号: P03309别名: PSF3应用: WB,IHC反应种属: Human, Mouse
-
分类: 科研抗体货号: P03226别名: INI; Rds3; SF3B7; SAP14b; SF3b14b; bK223H9.2应用: WB,IHC反应种属: Human, Mouse, Rat
-
分类: 科研抗体货号: P03280别名: TNN1; SSTNI应用: WB,IHC反应种属: Human, Mouse, Rat
-
分类: 科研抗体货号: P03308别名: HYPA; FBP11; FLAF1; FNBP3; HIP10; Prp40; FBP-11; HIP-10; NY-REN-6应用: WB,IHC反应种属: Human, Mouse

鄂公网安备42018502007531号
鄂公网安备42018502007531号

